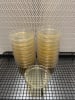
Inicio

Micelio Austral
Extractos de hongos adaptogenos
Gotarios de extractos medicinales de hongos con potenciadores adaptógenos, beneficiosos para la salud de las personas.
Categorías

Extractos de Hongos Adaptogenos

Grano Colonizado (SPAWN)